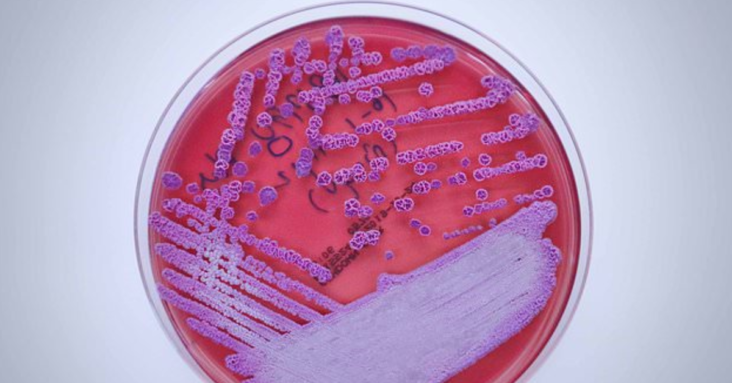
Deadly bacteria that causes meliodosis detected in Mississippi water, CDC reveals First time cause of disease similar to TB has ever been found in the US

- Bacteria that is responsible for the deadly infection meliodosis has been detected in the U.S. for the first time
- The CDC revealed that it was detected in water and soil in the Mississippi Gulf Coast region
- Cases in America are sporadic with around a dozen found every year, though they are usually borne in parts of the world where it is endemic
- Globally, the infection kills around 50% of people that it infects though medicine in developed world can slash that risk to only 10%
The bacteria responsible for a disease that kills up to 50 percent of the people it infects has been detected on U.S. soil for the first time, the Centers for Disease Control and Prevention (CDC) revealed Wednesday.
Burkholderia pseudomallei, the cause of meliodosis, has been detected in soil and water samples in the Mississippi Gulf Coast.
The bacteria was found as part of an investigation into two cases in the area that have been found in recent years. Around a dozen Americans catch the deadly disease yearly, but cases have always been tied to foreign travel.
It was previously thought not to be found in the U.S., but the find means Americans can now catch the disease at home. However, officials were quick to say the risk to the public remained ‘very low’.
Globally, half of patients that have confirmed infections eventually die as a result. Experts warned the detection was a ‘big deal’, as it told doctors to be on alert for the disease in local patients.
The Centers for Disease Control and Prevention (CDC) said in its alert it was ‘unclear’ how long the bacteria had been in America, or whether it was also in other states.
But they stressed that environmental conditions along the Gulf Coast are ‘conducive’ to the bacteria being able to survive.
The CDC launched an investigation earlier this year after two unrelated patients who lived near each other came down with melioidosis in 2020 and 2022.
Samples were taken from the soil and water around both patients homes, with three of those taken in 2022 testing positive for the bacteria.
Dr Julie Petras, an epidemiologist with the CDC, told STAT News the find was a ‘big deal’ because ‘clinicians… only consider melioidosis in patients who have recent travel to an endemic area’.
‘They would not consider just somebody living in the Gulf Coast area who has never traveled, that they would have melioidosis,’ she added.
‘So really the purpose of this [alert] is to say: Look, we found it here. It is locally endemic in this region. Be on alert. Because this disease can look like a lot of different things, so it can be challenging to diagnose.’
About 12 people are struck down with the disease in America every year, but until now these cases were nearly always linked to international travel.
Like many other bacterial infections, it is caused when a person exposed to the germs via infected soil or water.
Person-to-person transmission of the disease is possible but extremely rare.
The onset of symptoms can be sporadic with some feeling it as early as 24 hours after exposure and others not feeling sick for two-to-four weeks.
It is often initially mistaken for tuberculosis, pneumonia or other pulmonary issues by health professionals.
Around 50 percent of people infected will die, though the figure is likely tied to its prevalence in less-developed nations that may not have the same access to medicine that first world nations do.
In countries like the U.S., access to medicine drops the risk of death to around ten percent.